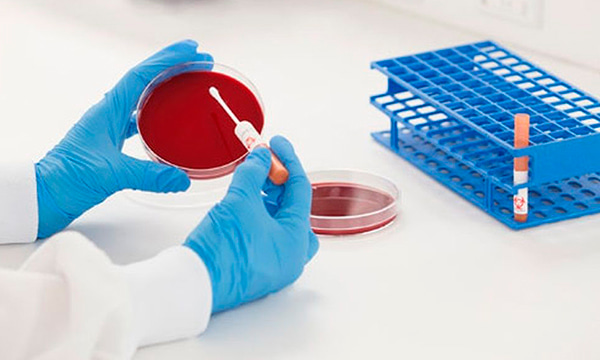
Анализ синовиальной жидкости на аэробные и факультативно-анаэробные микроорганизмы с определением чувствительности к антимикробным химиотерапевтическим препаратам

Анализ синовиальной жидкости на аэробные и факультативно-анаэробные микроорганизмы с определением чувствительности к антимикробным химиотерапевтическим препаратам в Уфе
Срок исполнения:
от 4 до 5 суток. Указанный срок не включает день взятия биоматериала
Стоимость услуги:
700 руб.
+ Взятие биоматериала у взрослых 400 руб.
Для записи на услугу может потребоваться предварительное посещение врача.
Почему нас выбирают
Быстрый результат
Вы получите результаты ваших анализов в кратчайшие сроки. Срок зависит от сложности проводимого исследования
Лучшие специалисты
Наши врачи лабораторной диагностики— лучшие специалисты с большим опытом работы
Собственная лаборатория
Вы можете быть уверены в результатах проведенных у нас анализов. Мы используем только качественное оборудование и реагенты
Удобный формат
Вы получите результаты и их расшифровку в удобном для вас формате